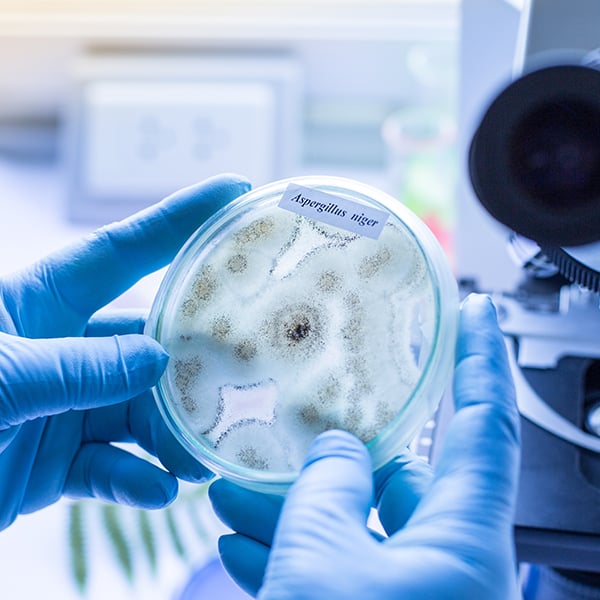
Empleabilidad

Curso de Enfermedades Infecciosas Causadas por Hongos

Certificación
Universidad Tecnológica Atlántico-Mediterráneo
El Curso de Enfermedades Infecciosas Causadas por Hongos está certificado con 100 Horas, 4 Créditos ECTS por la prestigiosa Universidad Tecnológica Atlántico-Mediterráneo.
La Universidad Tecnológica Atlántico Mediterráneo (UTAMED) es una institución de educación superior respaldada por la experiencia de un grupo educativo de España. Su propósito es ofrecer programas alineados con las necesidades del mercado laboral, priorizando la formación práctica y en habilidades.
La UTAMED busca que sus alumnos sean reconocidos por empresas e instituciones por sus competencias, fomentando la conexión entre investigación aplicada y sector empresarial para contribuir al desarrollo social, la competitividad y la solidaridad. Sus ejes principales son la tecnología, el emprendimiento, la innovación, la educación y la salud.

Modelo de diploma


Plan de estudios
Requisitos de acceso
- Copia del DNI, TIE o Pasaporte por ambas caras.
Plazo inscripción
La inscripción en esta formación 100% online con metodología E-Learning permanecerá abierta durante todo el año.
Duración
El discente tendrá un tiempo mínimo de 1 mes para la realización de este programa formativo y un máximo de 6 meses para su finalización.
Evaluación
La evaluación estará compuesta por:
- 59 Preguntas opción múltiple (a/b/c).
Todos los alumnos deben aprobar la evaluación correspondiente a cada tema, en caso de no superar el total de las evaluaciones conjuntamente, el alumno dispone de una segunda oportunidad sin coste adicional.
Este programa formativo online con metodología E-Learning está destinado a todo aquel profesional de:
- Graduados/as en farmacia.
- Graduados/as en medicina.
- Técnicos superior.
- Graduados/as en enfermería.
- Biólogos en ciencias de la salud.
Objetivos generales:
- Tomar contacto con las características de los hongos, grandes desconocidos de la microbiología clínica.
- Analizar la clasificación y morfología de los distintos hongos.
- Estudiar el proceso de recogida, transporte y procesamiento de muestras para el estudio de infecciones fúngicas, así como los métodos de detección e identificación de los hongos.
- Profundizar en las infecciones fúngicas más frecuentes y que causan mas morbi-mortalidad en la actualidad.
Objetivos específicos:
- Adquirir conocimientos sobre la clasificación y morfología de los hongos.
- Aprender las técnicas adecuadas para la recogida, transporte y procesamiento de muestras para el estudio de infecciones fúngicas.
- Conocer los diferentes métodos de detección e identificación de los hongos.
- Identificar los agentes productores de dermatofitosis y micosis superficiales.
- Describir las características y tratamientos de las infecciones por Absidia, Rhizopus, Rhizomucor y otras zigomicosis.
- Conocer los hongos productores de micosis sistémicas y su dimorfismo.
- Identificar los hongos dematiáceos y su relación con las infecciones.
- Aprender sobre los hongos causantes de micetoma eumicótico y su tratamiento.
- Describir las infecciones producidas por levaduras como Candida y Cryptococcus.
- Conocer las características de las infecciones producidas por Pneumocystis.
- Identificar las infecciones producidas por Aspergillus y otros hongos oportunistas.
- Aprender sobre los fármacos antifúngicos y los mecanismos de resistencia.
- Adquirir conocimientos sobre los métodos de estudio de sensibilidad a los antifúngicos.
Competencias generales
- Identificar y clasificar los distintos tipos de hongos y comprender su morfología.
- Aplicar técnicas adecuadas para la recolección, transporte y procesamiento de muestras relacionadas con infecciones fúngicas.
- Utilizar métodos de detección e identificación de los hongos, incluyendo técnicas moleculares y microbiológicas.
- Conocer los agentes causantes de dermatofitosis y micosis superficiales, así como su diagnóstico y tratamiento.
- Analizar las características, diagnóstico y tratamiento de infecciones causadas por Absidia, Rhizopus, Rhizomucor y otras zigomicosis.
- Estudiar los hongos productores de micosis sistémicas y comprender su dimorfismo.
- Evaluar las características, diagnóstico y tratamiento de las infecciones causadas por hongos dematiáceos.
- Identificar los hongos causantes de micetoma eumicótico y conocer sus métodos de diagnóstico y tratamiento.
- Comprender las características, diagnóstico y tratamiento de las infecciones producidas por levaduras como Candida y Cryptococcus.
- Analizar las infecciones producidas por Pneumocystis y conocer su diagnóstico y tratamiento.
- Estudiar las infecciones producidas por Aspergillus y otros hongos oportunistas, así como las medidas de diagnóstico y tratamiento.
- Conocer los fármacos antifúngicos disponibles y comprender los mecanismos de resistencia a los mismos.
- Aplicar técnicas de estudio de sensibilidad a antifúngicos para evaluar la eficacia de los tratamientos.
Competencias profesionales
- Habilidades críticas y autocríticas.
- Resolución de problemas.
- Gestión y manejo de información interdisciplinarios.
- Comprensión de diversidad y multiculturalidad.
- Diseño y gestión de proyectos.
- Capacidad de trabajar de manera autónoma.
- Capacidad de aplicar los conocimientos adquiridos al trabajo profesional del personal sanitario desde una perspectiva globalizadora.
- Capacidad para observar, analizar y documentar procesos educativos.
- Trabajo en equipo.
Temario
- Tema I. Clasificación y morfología de los hongos.
- Tema II. Recogida, transporte y procesamiento de muestras para el estudio de infecciones fúngicas.
- Tema III. Métodos de detección e identificación de los hongos.
- Tema IV. Agentes productores de dermatofitosis y micosis superficiales.
- Tema V. Infecciones por Absidia, Rhizopus, Rhizomucor y otras zigomicosis.
- Tema VI. Hongos productores de micosis sistémicas. Hongos dimórficos.
- Tema VII. Hongos dematiáceos.
- Tema VIII. Hongos causantes de micetoma eumicótico.
- Tema IX. Infecciones producidas por levaduras: Candida y Cryptococcus.
- Tema X. Infecciones producidas por Pneumocystis.
- Tema XI. Infecciones producidas por Aspergillus y otros hongos oportunistas.
- Tema XII. Fármacos antifúngicos. Mecanismos de resistencia.
- Tema XIII. Métodos de estudio de sensibilidad a antifúngicos.
Metodología
Tu formación a distancia se adapta a ti gracias a nuestra plataforma online. Podrás acceder al contenido, descargar materiales y realizar tu formación desde cualquier lugar, sin barreras.
Empleabilidad
La orientación profesional tiene el objetivo de responder a la creciente demanda de los profesionales por adquirir las competencias y habilidades necesarias para desarrollar las actividades específicas de su ámbito laboral con las mayores garantías de éxito y calidad. Estas competencias permiten que estos profesionales se conviertan en referentes en la excelencia de los cuidados en diversas áreas.
En este sentido, nuestros programas formativos están diseñados y elaborados por profesionales de la salud con años de experiencia, por lo que están enfocados a que los alumnos adquieran esas competencias y habilidades prácticas.
¿Qué beneficios puedes obtener al realizar uno de nuestros programas formativos?
- Especialización en un ámbito o tema concreto.
- Actualización de conocimientos y puesta al día.
- Creación y ampliación de una red de contactos.
- Excelencia y referencia profesional.
- Mejora del currículum vitae.
- Posibilidades de promocionar en tu puesto laboral.